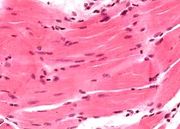

Спорт-вики — википедия научного бодибилдинга
Список файлов
Эта служебная страница показывает все загруженные файлы.
| Дата | Имя файла | Миниатюра | Размер | Участник | Описание | Версий |
|---|---|---|---|---|---|---|
| 10:11, 20 июля 2016 | Mishci sport90.jpg (файл) |  |
36 КБ | Anes | Частота сердечных сокращений при неутомительной и изматывающей физической нагрузке. При неутомительной нагрузке сердечные сокращения… | 1 |
| 09:46, 20 июля 2016 | Mishci sport89.jpg (файл) |  |
15 КБ | Anes | Определение анаэробного порога при велоэргометрии. Анаэробный порог — максимальная нагрузка, при которой концентрация лактата в крови… | 1 |
| 09:41, 20 июля 2016 | Mishci sport88.jpg (файл) |  |
18 КБ | Anes | Потребление кислорода, минутный объем дыхания и дыхательный коэффициент при умеренной физической нагрузке (200 Вт (Старт)). Отмечены дефиц… | 1 |
| 09:08, 20 июля 2016 | Mishci sport86.jpg (файл) |  |
11 КБ | Anes | Факторы, влияющие на энергетический обмен | 1 |
| 09:07, 20 июля 2016 | Mishci sport85.jpg (файл) |  |
22 КБ | Anes | Пути энергообеспечения мышечной ткани | 1 |
| 05:55, 20 июля 2016 | Mishci sport84.jpg (файл) |  |
9 КБ | Anes | Влияние предварительного растяжения на силу сокращения мышцы. Предварительное растяжение повышает напряжение мышцы. Результирующая кр… | 1 |
| 05:55, 20 июля 2016 | Mishci sport83.jpg (файл) |  |
7 КБ | Anes | Зависимость скорости укорочения от нагрузки | 1 |
| 05:53, 20 июля 2016 | Mishci sport82.jpg (файл) |  |
9 КБ | Anes | Зависимость силы сокращений от длины саркомера | 1 |
| 05:51, 20 июля 2016 | Mishci sport81.jpg (файл) |  |
22 КБ | Anes | Схема образования поперечных связей — молекулярной основы сокращения саркомера | 1 |
| 05:48, 20 июля 2016 | Mishci sport80.jpg (файл) |  |
25 КБ | Anes | 2 | |
| 05:46, 20 июля 2016 | Mishci sport79.jpg (файл) |  |
13 КБ | Anes | Электрическое раздражение и мышечный ответ. Сверху показаны электрические импульсы, снизу — ответ мышцы | 1 |
| 05:18, 20 июля 2016 | Mishci sport78.jpg (файл) |  |
49 КБ | Anes | Передача сигнала на двигательной концевой пластинке | 1 |
| 05:13, 20 июля 2016 | Mishci sport76.jpg (файл) |  |
9 КБ | Anes | Потенциал действия | 1 |
| 03:24, 20 июля 2016 | Mishci sport75.jpg (файл) |  |
53 КБ | Anes | Микроскопическое строение кардиомиоцита | 1 |
| 03:23, 20 июля 2016 | Mishci sport74.jpg (файл) |  |
39 КБ | Anes | Входной и выходной потоки ионов Са2+ в электромеханическом сопряжении при сокращении сердца | 1 |
| 03:20, 20 июля 2016 | Mishci sport73.jpg (файл) |  |
13 КБ | Anes | Потенциалы действия сердца и скелетных мышц | 1 |
| 03:19, 20 июля 2016 | Mishci sport72.jpg (файл) |  |
34 КБ | Anes | Электрокардиограмма сердца | 1 |
| 01:14, 20 июля 2016 | Mishci sport71.jpg (файл) |  |
46 КБ | Anes | Строение проводящей системы сердца | 1 |
| 01:10, 20 июля 2016 | Mishci sport70.jpg (файл) |  |
18 КБ | Anes | Поперечный срез через желудочки сердца | 1 |
| 01:09, 20 июля 2016 | Mishci sport69.jpg (файл) |  |
46 КБ | Anes | Строение сердца | 1 |
| 11:40, 19 июля 2016 | Mishci sport68.jpg (файл) |  |
42 КБ | Anes | Послойное строение стенки кровеносного сосуда | 1 |
| 11:39, 19 июля 2016 | Mishci sport67.jpg (файл) |  |
73 КБ | Anes | Кровеносная система человека: красный — артерии, синий — вены | 1 |
| 11:31, 19 июля 2016 | Mishci sport66.jpg (файл) |  |
57 КБ | Anes | Схематическое изображение ультраструктуры гладкомышечной клетки | 1 |
| 11:30, 19 июля 2016 | Mishci sport65.jpg (файл) | |
11 КБ | Anes | Гистологическое строение гладких мышц — гладкомышечные веретенообразные клетки с одиночным расположенным в центре ядром; миофибриллы… | 1 |
| 11:29, 19 июля 2016 | Mishci sport64.jpg (файл) |  |
17 КБ | Anes | Типичные формы гладкомышечных клеток: а —длинные веретенообразные (стенка кишки); б —короткие фестончатые (стенка аорты); в — звездчатые… | 1 |
| 04:49, 19 июля 2016 | Mishci sport17.jpg (файл) |  |
110 КБ | Anes | Типы мышц | 1 |
| 04:43, 19 июля 2016 | Mishci sport16.jpg (файл) |  |
31 КБ | Anes | Непрямое мышечно-сухожильное соединение, поверхностная часть | 1 |
| 04:42, 19 июля 2016 | Mishci sport15.jpg (файл) |  |
43 КБ | Anes | Прямое костно-сухожильное соединение | 1 |
| 04:39, 19 июля 2016 | Mishci sport14.jpg (файл) |  |
30 КБ | Anes | Строение сухожильного влагалища | 1 |
| 04:36, 19 июля 2016 | Mishci sport13.jpg (файл) |  |
101 КБ | Anes | Расположение коллагеновых волокон в сухожилии | 1 |
| 04:33, 19 июля 2016 | Mishci sport12.jpg (файл) |  |
80 КБ | Anes | Строение коллагенового волокна | 1 |
| 04:28, 19 июля 2016 | Mishci sport11.jpg (файл) |  |
63 КБ | Anes | Строение мышечно-сухожильного соединения | 1 |
| 04:26, 19 июля 2016 | Mishci sport10.jpg (файл) |  |
23 КБ | Anes | Принцип аутогенного торможения | 1 |
| 04:24, 19 июля 2016 | Mishci sport8.jpg (файл) |  |
34 КБ | Anes | Рис. 1.6 в. Строение и функция мышечного веретена: реципрокное и возвратное ингибирование | 1 |
| 04:23, 19 июля 2016 | Mishci sport9.jpg (файл) |  |
25 КБ | Anes | Рис. 1.7 а. Сухожильные органы Гольджи | 1 |
| 04:21, 19 июля 2016 | Mishci sport7.jpg (файл) |  |
24 КБ | Anes | Рис. 1.6 б. Строение и функция мышечного веретена: моносинаптический проприоцептивный рефлекс | 1 |
| 04:19, 19 июля 2016 | Mishci sport6.jpg (файл) |  |
55 КБ | Anes | Строение и функция мышечного веретена: кольцеспиральные нервные окончания 1а-волокон (Аа-волокна) | 1 |
| 04:10, 19 июля 2016 | Mishci sport5.jpg (файл) |  |
41 КБ | Anes | Моторная единица | 1 |
| 03:52, 19 июля 2016 | Mishci sport4.jpg (файл) |  |
20 КБ | Anes | Сарколемма и базальная мембрана | 1 |
| 03:47, 19 июля 2016 | Mishci sport3.jpg (файл) |  |
96 КБ | Anes | Строение саркоплазматического ретикулума и системы поперечных Т-трубочек | 1 |
| 03:44, 19 июля 2016 | Mishci sport2.jpg (файл) |  |
74 КБ | Anes | Белки саркомера | 1 |
| 03:43, 19 июля 2016 | Mishci sport1.jpg (файл) |  |
48 КБ | Anes | Строение поперечно-полосатых скелетных мышц | 1 |
| 13:59, 18 июля 2016 | Nabieva do posle.jpg (файл) |  |
419 КБ | Ars | Бахар Набиева (фото до и после) | 1 |
| 07:28, 17 июля 2016 | Vaginich2.jpg (файл) |  |
23 КБ | Anes | Вагиныч прикрыла - Бахар Набиева (оригинальное фото) | 1 |
| 06:36, 17 июля 2016 | Vaginich.jpg (файл) |  |
37 КБ | Anes | "Вагиныч прикрыт" Бахар Набиева | 1 |
| 06:31, 17 июля 2016 | Nabieva privat.jpg (файл) |  |
84 КБ | Anes | Приватное видео Бахар Набиевой | 1 |
| 06:27, 17 июля 2016 | Nabieva.jpg (файл) |  |
119 КБ | Anes | Бахар Набиева (июнь 2016) | 1 |
| 02:33, 17 июля 2016 | Ab Gymnic 2.jpg (файл) |  |
65 КБ | Django | Методы "прокачки" всего тела с помощью Ab Gymnic | 1 |
| 02:32, 17 июля 2016 | Ab Gymnic 1.jpg (файл) |  |
165 КБ | Django | Прибор Ab Gymnic | 1 |
| 02:51, 16 июля 2016 | Explosive Calisthenics24.jpg (файл) |  |
93 КБ | Anes | Прыжки через ногу с упором в стену | 1 |
